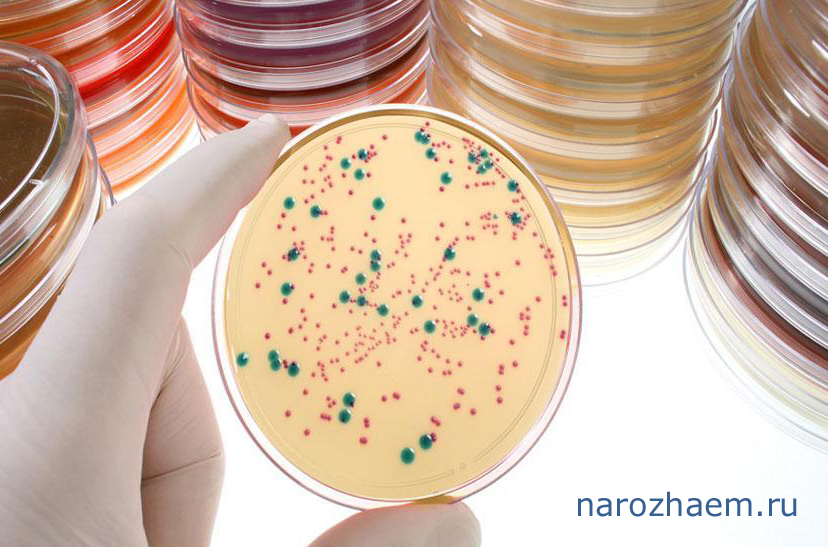

Стимуляция яичников — что это такое?

Каким образом стимулируют овуляцию?
Стимуляция овуляции – метод лечения при бесплодии
Бесплодие – одна из самых распространенных проблем современности. Изменившиеся условия окружающей среды, постоянные стрессовые ситуации и технологический прогресс ведут к тому, что возраст женщины, созревшей для беременности и родов, увеличивается. Соответственно, возникает больше проблем по зачатию и вынашиванию ребенка. Одним из методов, помогающим женщине забеременеть, является стимуляция овуляции.
С момента зачатия у каждой девочки имеется так называемый «овариальный резерв», состоящий из яйцеклеток, которые в период полового созревания приводят к овуляторным циклам. Именно в такие циклы женщина может забеременеть.
Регуляция менструального цикла
Регуляция менструального цикла происходит на пяти уровнях.
Первый уровень – это так называемые органы-мишени, на которые прямое воздействие оказывают половые гормоны. К ним относятся женские половые органы, жировая ткань и молочные железы.
Второй уровень – это яичники, вырабатывающие женские половые гормоны эстрогены и прогестерон. В яичниках происходит созревание яйцеклетки. И под воздействием гормонов происходит овуляция.
Третий уровень – это гипофиз, структура головного мозга, вырабатывающая ФСГ (фолликулостимулирующий) и ЛГ (лютеинизирующий) гормоны, ответственные за стимуляцию роста фолликула и его созревание. Кроме того, здесь вырабатывается окситоцин и пролактин, необходимые для поддержания беременности, индукции родов и выработки молока.
Четвертый уровень – это гипоталамус, в котором происходит выработка рилизинг-гормонов, благодаря чему менструации возникают регулярно с определенной цикличностью.
Пятый уровень – это кора головного мозга, которая регулирует все процессы, происходящие в женском организме.
Нарушение менструального цикла может возникать на любом из пяти уровней, что ведет к ановуляторным циклам, когда яйцеклетка не созревает и беременность не наступает.
Выделяют два понятия ановуляции: физиологическая и патологическая.
Физиологическая ановуляция может возникать у любой женщины в результате стрессов, заболеваний или каких-либо факторов окружающей среды. Однако, на смену ановуляции приходит созревание яйцеклетки.

Что называют бесплодием?
Что такое бесплодие
Бесплодием по рекомендациям ВОЗ принято считать не наступление беременности в течение одного года и более при регулярной незащищенной половой жизни или через 6 месяцев, если возраст свыше 35 лет.
Если при обследовании бесплодной пары спермограмма мужа без патологии, а у женщины овуляция происходит редко или не наступает вовсе, можно воспользоваться методом стимуляции овуляции.
Для того, чтобы определить, наступает ли у женщины овуляция, проводят тесты на овуляцию. Можно применять тест-полоски, а можно воспользоваться методом УЗИ. При УЗИ-контроле можно видеть доминантный фолликул и прогнозировать его овуляцию.
Стимуляция овуляции – это метод стимуляции яичников медикаментозными препаратами, которые позволяют имитировать нормальный менструальный цикл и обеспечить созревание яйцеклетки.
Показания для стимуляции овуляции
Показаниями для стимуляции созревания яйцеклетки становятся доказанные ановуляторные или редкие овуляторные циклы.
Для того, чтобы подтвердить отсутствие овуляции используются следующие методы:
- измерение базальной температуры. Преимущество – дешевизна и применение в домашних условиях. Недостаток – применение ежедневно не менее трех циклов, недостоверность результатов из-за субъективности метода. Может использоваться как дополнительный метод обследования;
- тест-полоски на овуляцию, которые работают по принципу тестов на беременность: когда овуляция произошла, тест показывает 2 полоски. Преимущества метода – возможность применять его в домашних условиях. Недостатки – дороговизна и необходимость применять тест каждый день в течение трех менструальных циклов;
- гормональные исследования на половые гормоны позволяют выявить недостаточность или избыток гормонов;
- УЗИ-мониторинг, или фолликулометрия. При этом производится измерение фолликулов в яичниках в течение цикла. Производится также не менее трех менструальных циклов подряд. Недостаток – необходимо иметь время на проведение исследования.
После УЗИ могут быть выставлены диагнозы:
- ановуляция, когда доминантный фолликул не развивается;
- недостаточное развитие доминантного фолликула, когда он растет и, не достигая необходимой величины, регрессирует;
- происходит развитие доминантного фолликула, но он не достигает необходимой величины, в результате чего превращается в желтое тело;
- развитие доминантного фолликула происходит, величина его соответствует норме, но не происходит овуляция. При этом стимулировать процесс не нужно, достаточно терапия для разрыва фолликула введением ХГЧ;
- развитие доминатного фолликула соответствует норме, овуляция происходит и на его месте образуется желтое тело. Это говорит о нормальном созревании яйцеклеток. Лечение не требуется.
Стимулировать овуляцию необходимо в первых трех случаях.
Какие обследования необходимо пройти?
Обследования перед проведением стимуляции овуляции
Перед тем, как проводить процедуру стимуляции овуляции, необходимо пройти следующее обследование:
- спермограмма мужа;
- кровь на ВИЧ, HBsAg, HCV;
- кровь на сифилис;
- мазок на флору;
- мазок на онкоцитологию;
- посев из влагалища на специфические инфекции, передающиеся половым путем (методом ПЦР хламидии и герпес, ВПЧ 16 и 18 тип, посев на микоплазму, уреаплазму);
- анализ крови на половые гормоны;
- анализ крови на гормоны щитовидной железы;
- УЗИ молочных желез;
- УЗИ органов малого таза;
- ЭКГ;
- осмотр терапевта с заключением об экстрагениальной патологии и возможностью к беременности;
- метросальпингография – метод оценки проходимости маточных труб;
- лапароскопия;
- гистероскопия по показаниям.
Проходимость маточных труб необходима для того, чтобы исключить возможность развития внематочной беременности, так как оплодотворение яйцеклетки происходит в них.
Противопоказания для стимуляции овуляции
Стимуляция овуляции может быть выполнена не каждой женщине. Как и любое другое медицинское вмешательство, данная процедура имеет свои противопоказания, которые могут быть абсолютными и относительными.
При абсолютных противопоказаниях стимуляция яичников запрещена, а при относительных – необходимо соблюдение каких-либо условий, чтобы она была произведена.
Среди абсолютных противопоказаний выделяют:
- генетические мутации, включающие в себя аномалии генные и хромосомные;
- наследственные заболевания в семьях пары;
- непроходимость обеих маточных труб;
- ограничения по возрасту и соматическому здоровью;
- тяжелые экстрагенитальные заболевания: заболевания сердца, почек, печени, которые могут привести к тяжелым последствиям как стимуляции, так и наступившей беременности.
Среди относительных противопоказаний выделяют:
- воспалительные заболевания женских половых органов: сальпингиты, оофориты, сальпингоофориты, эндометриты;
- инфекции, передающиеся половым путем;
- непроходимость одной маточной трубы без патологических изменений второй трубы после удаления измененных придатков для исключения развития внематочной беременности;
- синдром гиперстимуляции яичников, который возникает в результате повышенного уровня половых гормонов или гормонов гипофиза и проявляется характерной клинической картиной с отеком яичников.

Основные схемы стимуляции овуляции
Основные схемы стимуляции овуляции
Стимуляция для получения овуляции производится медикаментозно разрешенными в стране препаратами.
Стимуляцию производят по трем схемам, для чего используют две группы препаратов.
Схема №1
К первой группе относят препараты с прямым действием, влияющие на третий и четвертый уровни регуляции менструального цикла: гипоталамус и гипофиз. При воздействии на эти органы, усиливается выброс гормонов, которые воздействуют на яичники. При этом достигается необходимый эффект.
Среди препаратов первой группы наибольшее распространение получил Кломифена цитрат, или Клостилбегит.
Стимулирование овуляции начинают со 2 по 5 дни после начала месячных. Назначают препарат на 5 дней в дозировке по таблетке 1 раз в сутки.
Для подтверждения наступления овуляции проводят УЗИ контроль, наблюдая за ростом доминантного фолликула и увеличением толщины эндометрия на 7 – 11, 14 – 16 дни от первого дня менструации при стандартном цикле 28 – 30 дней. Если цикл длиннее или короче, замеры производят по индивидуальному плану.
Как правило, в середине цикла (14 – 16 дни) фолликул созревает. В это же время вводится Хорионический гонадотропин, или Прегнил. Этот препарат позволяет выйти созревшей яйцеклетки из фолликула. Для зачатия необходим половой акт в течение двух дней.
УЗИ проводят на 17 – 19 дни. С 16 дня присоединяют препараты прогестерона, такие как, Дюфастон, Утрожестан, Крайнон от 10 дней до двух недель. Этот препарат позволяет сохранить и пролонгировать беременность.
Перед предполагаемыми месячными женщина делает тест на беременность, а после семидневной задержки сдает кровь на хорионический гонадотропин (ХГ) и выполняет УЗИ.
Кломифен относится к группе препаратов антиэстрогенного действия. При зачатии возрастает риск невынашивания беременности из-за нарушения свойств слизи цервикального канала, что неблагоприятного влияет на подвижность сперматозоидов, и тонкого эндометрия, что затрудняет закрепление оплодотворенной сперматозоидом яйцеклетки к стенке матки. Для того, чтобы избежать побочного действия, назначаются препараты эстрогенов, такие как Микрофоллин или Прогинова.
Если беременность не наступает в первом цикле стимуляции, то далее увеличивают дозу Кломифена.
Если эффекта от стимуляции нет вовсе, то переходят на препараты гонадотропинов.
Схема №2
Препараты второй группы относятся к гонадотропинам, которые в норме вырабатываются в гипофизе. Наиболее часто применяют Пурегон, Меногон, Гонал.
Стимуляцию начинают со 2 – 3 дня после начала месячных с обязательным УЗИ контролем на 6 – 7, 9 – 11, 13 – 16 дни, что позволяет подобрать необходимую дозировку средства, имитируя естественный циклический процесс. Инъекции делают ежедневно в одно и то же время для достижения наилучшего эффекта.
Далее все соответствует схеме №1.
Схема №3
Третья схема сочетает в себе комбинирование первой и второй группы.
Стимуляцию начинают с назначения Кломифена со 2 – 5 дня от первого дня месячных в течение 5 дней. Затем вводятся гонадотропины еще от 5 до 7 дней. После этого назначается хорионический гонадотропин, половой акт и поддерживающая терапия прогестероном. Далее все соответствует предыдущим схемам стимуляции.
Побочные эффекты препаратов для стимуляции овуляции
Среди побочных эффектов для стимуляции овуляции выделяют:
- сниженную чувствительность или отсутствие ее на введение препарата, что требует увеличение дозы;
- гиперчувствительность к средству, что может привести к синдрому гиперстимуляции яичников, что требует лечения в стационаре;
- аллергические реакции;
- многоплодная беременность, так как может созреть и оплодотвориться несколько яйцеклеток.
Стимуляция созревания яйцеклеток перед ЭКО
В случае, когда женщина идет на процедуру ЭКО, также производят стимуляцию овуляции, чтобы произвести забор нескольких яйцеклеток, тем самым увеличив при этом шанс на беременность.
После стимуляции лекарственными препаратами на 19 – 23 дни цикла после УЗИ контроля и достижении яйцеклетками необходимых размеров производится пункция яичника. Забранные яйцеклетки оплодотворяются и через 2 – 5 дней эмбрионы переносятся в матку. Далее проводится терапия по сохранению и пролонгированию беременности.